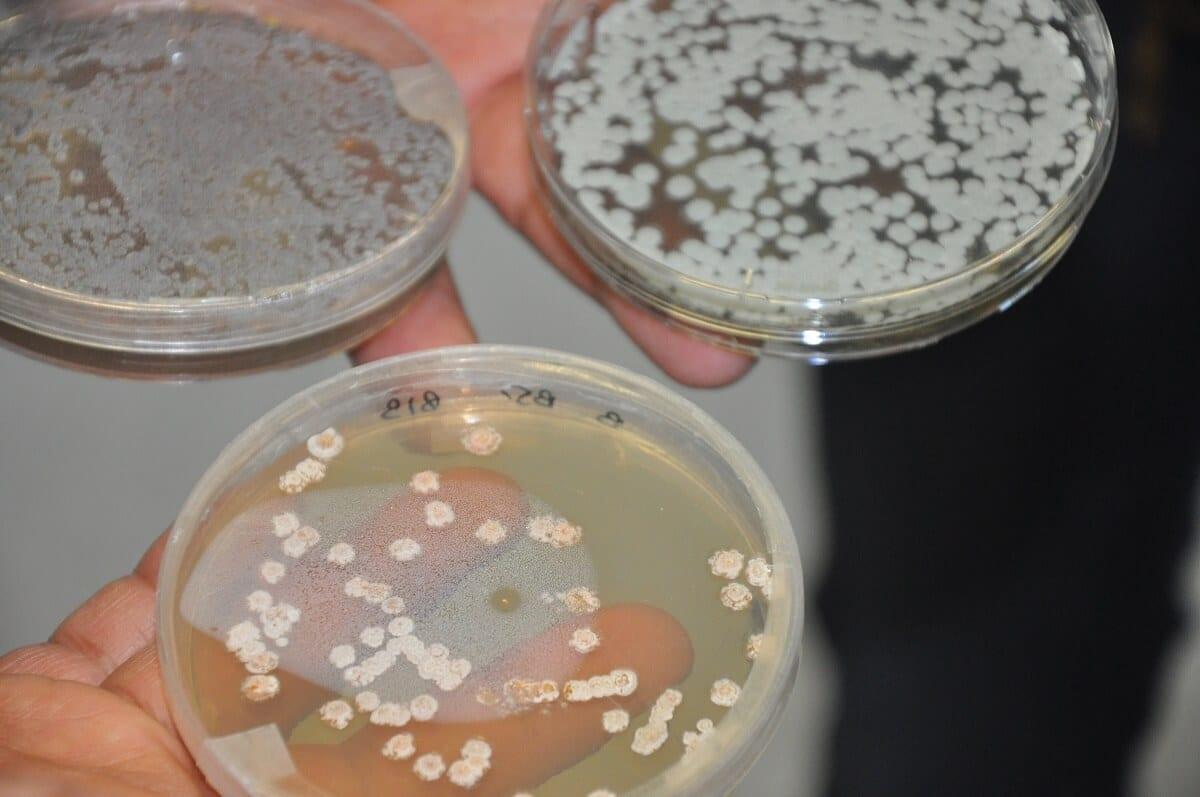
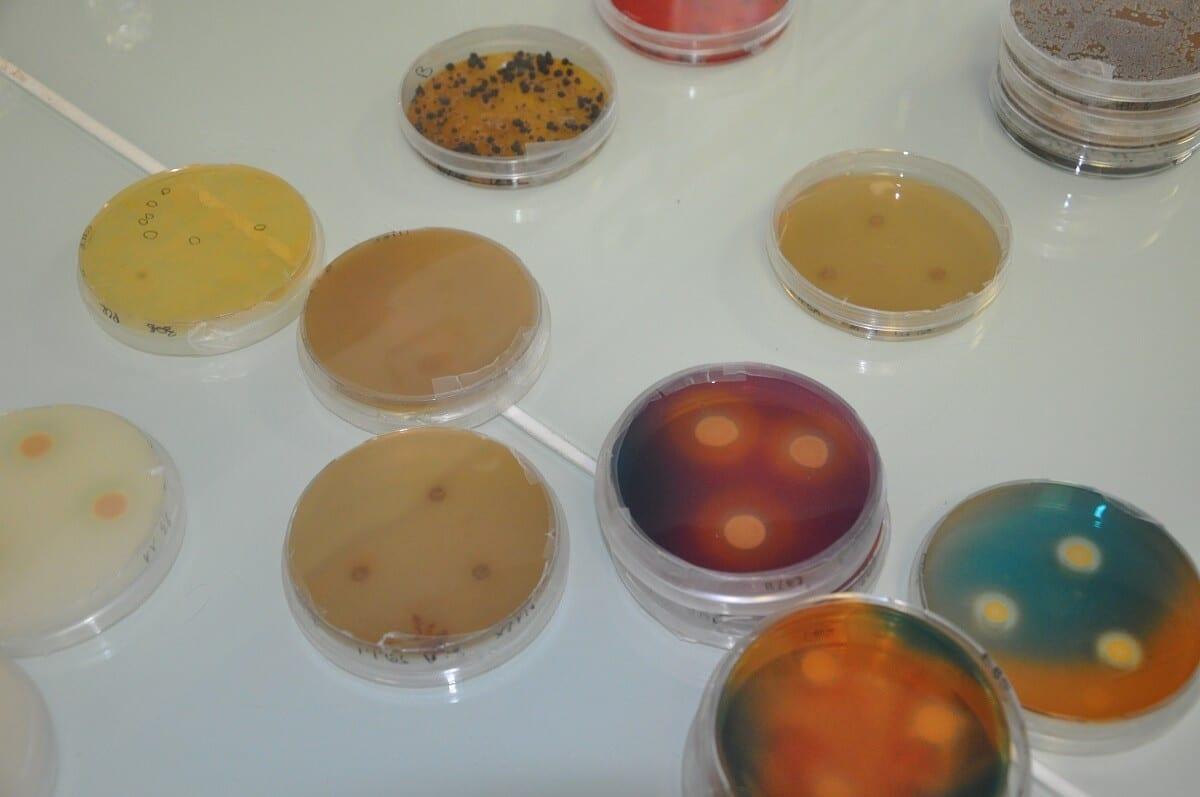
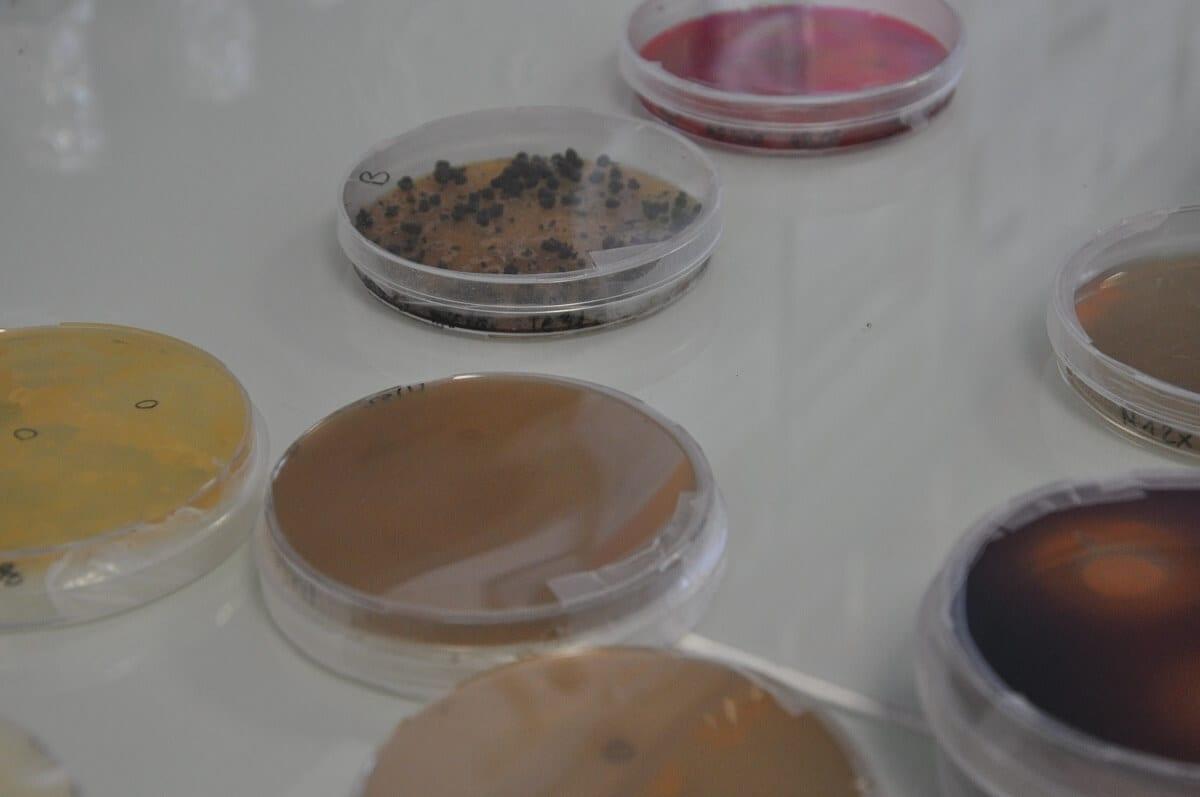
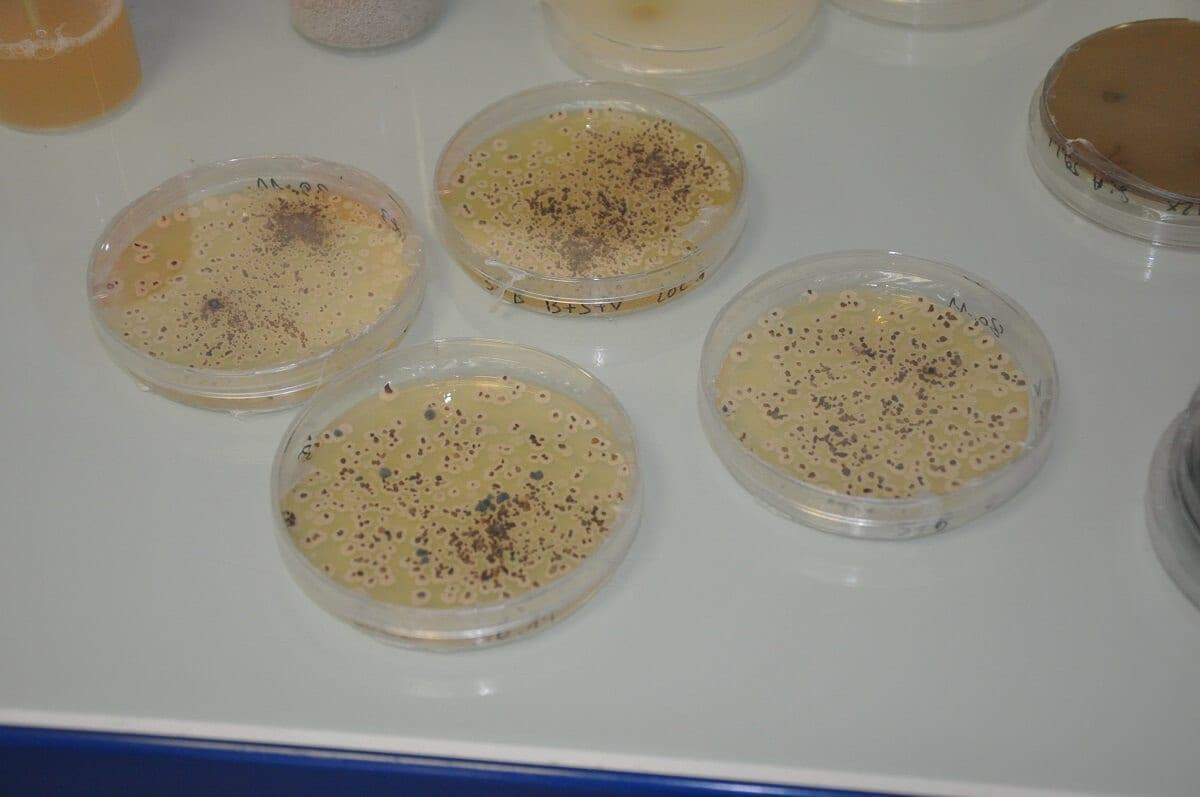
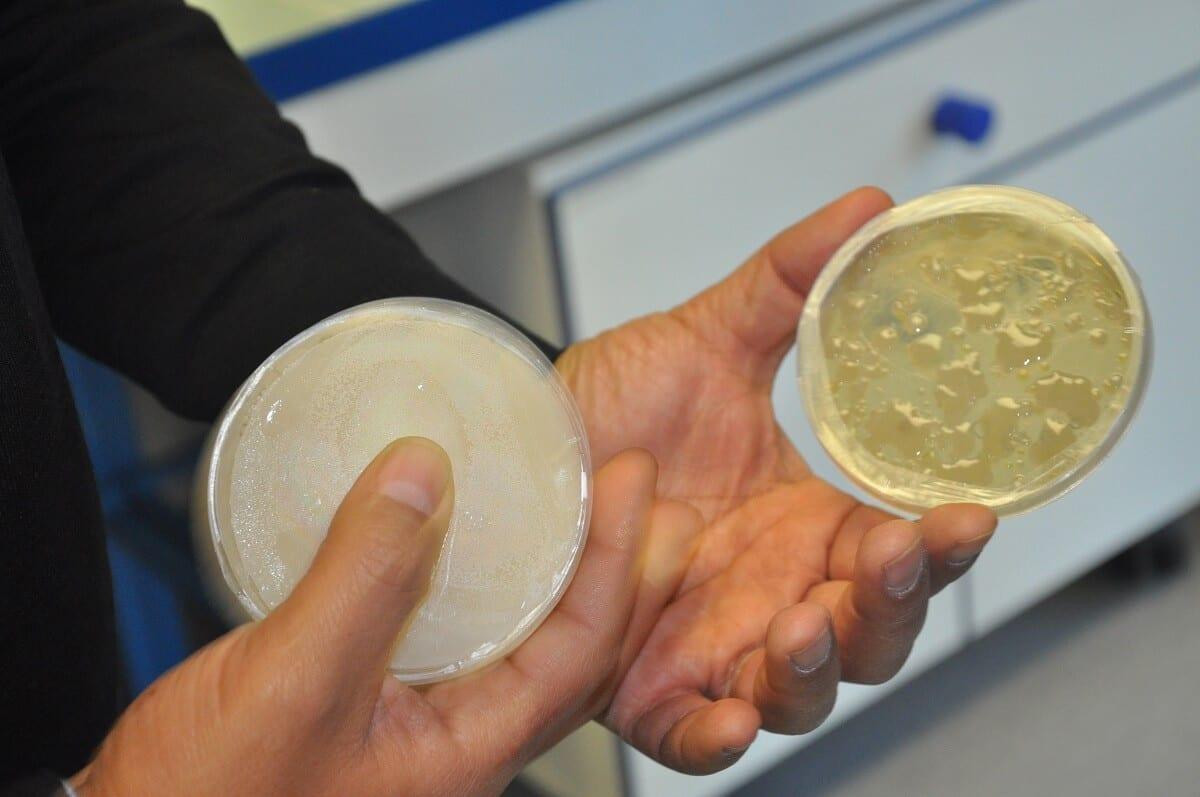
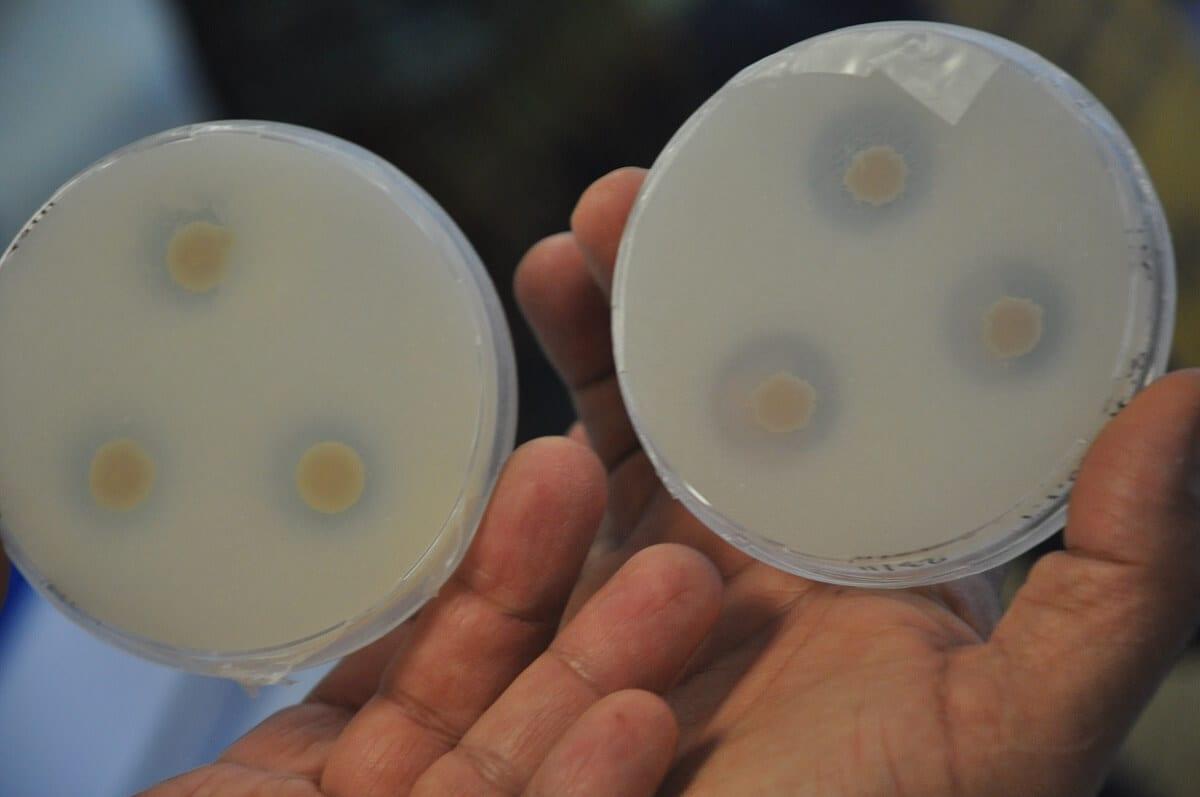

W malowniczym rejonie Tuluzy, stolicy francuskiej Oksytanii zlokalizowane są zakłady produkcyjne oraz laboratoria firmy Agronutrition (należącej do grupy de Sangosse), działającej w branży szeroko pojętego odżywiania roślin uprawnych. Firma oferuje swoje produkty w ponad 50 krajach świata, jest prekursorem dolistnego odżywiana roślin.
W grudniu br. na zaproszenie francuskiego lidera w produkcji biostymulatorów (25% rodzimego rynku), ale też nawozów w postaci mikrogranulatu, produktów na bazie wyciągów z alg i aminokwasów oraz zawierających pożyteczne mikroorganizmy (bakterie i grzyby) grupa dziennikarzy z Polski miała okazję zobaczyć jakie rozwiązania firma Agronutrition proponuje ogrodnikom. W Polsce znane są takie produkty firmy jak: Microstar PZ, Azofol, Nectar Intense.
Tekst i fot. J. Klepacz-Baniak
01 - Published up: 2026-05-07 09:52:43 - Modified: 2026-05-07 09:52:43 - Feat.: - Title: Ogórek gruntowy ma potencjał na 100 t/ha. Co go blokuje?
02 - Published up: 2026-05-06 09:03:20 - Modified: 2026-05-06 09:03:20 - Feat.: - Title: Nawóz na ziemniaki a wysokie plony: czy CRF może zastąpić część azotu?
03 - Published up: 2026-04-29 19:00:31 - Modified: 2026-04-29 19:00:31 - Feat.: - Title: Nawet 70% dopłat do paliwa i nawozów. Dali zielone światło – co zrobi Polska?
01 - Published up: 2023-07-25 08:02:05 - Modified: 2023-07-25 08:02:05 - Feat.: 0 - Title: Dzień Ogórka w Szarkówce, 23.07.2023 [zdjęcia]
02 - Published up: 2023-06-09 09:16:14 - Modified: 2023-06-09 09:16:14 - Feat.: 0 - Title: Spotkanie producentów ogórka i pomidora w Iwkowej
03 - Published up: 2023-05-30 14:07:44 - Modified: 2023-05-30 14:07:44 - Feat.: 0 - Title: Targi rolnicze Agriplanta - RomAgroTec w Fundulea w Rumunii
04 - Published up: 2023-05-15 13:26:10 - Modified: 2023-05-15 13:26:10 - Feat.: 0 - Title: Bocheński biznes pomidorowy [zdjęcia]
05 - Published up: 2023-05-08 16:28:56 - Modified: 2023-05-08 16:28:56 - Feat.: 0 - Title: Wielka Majówka Timac Agro Polska
06 - Published up: 2023-05-04 09:13:38 - Modified: 2023-05-04 09:13:38 - Feat.: 0 - Title: Macfrut 2023 - warzywnicze ciekawostki [zdjęcia]
07 - Published up: 2023-05-03 20:12:11 - Modified: 2023-05-03 20:12:11 - Feat.: 0 - Title: Targi MACFRUT 2023, Rimini. Pierwszy dzień targów już za nami [zdjęcia]
08 - Published up: 2023-04-27 16:25:05 - Modified: 2023-04-27 16:25:05 - Feat.: 0 - Title: Agraria 2023 w Rumunii [zdjęcia]
09 - Published up: 2023-04-04 08:59:28 - Modified: 2023-04-04 08:59:28 - Feat.: 0 - Title: Wiosenne Targi Rolno-Ogrodnicze Agromarsz
10 - Published up: 2023-03-21 21:12:51 - Modified: 2023-03-21 21:12:51 - Feat.: 0 - Title: Kieleckie targi AGROTECH 2023 - warzywnicze akcenty [galeria]
11 - Published up: 2023-01-20 15:42:34 - Modified: 2023-01-20 15:42:34 - Feat.: 0 - Title: 13. edycja Targów Sadownictwa i Warzywnictwa - fotorelacja
12 - Published up: 2023-01-13 18:12:31 - Modified: 2023-01-13 18:12:31 - Feat.: 0 - Title: AGRO PREMIERY 2023 w Poznaniu
13 - Published up: 2022-11-07 14:44:53 - Modified: 2022-11-07 14:44:53 - Feat.: 0 - Title: Marchew idealna na przemysł
14 - Published up: 2022-09-14 13:18:25 - Modified: 2022-09-14 13:18:25 - Feat.: 0 - Title: Bardzo dobre ceny cebuli
15 - Published up: 2022-09-12 17:37:39 - Modified: 2022-09-12 17:37:39 - Feat.: 0 - Title: Dni Ogrodnika 2022 - w obiektywie redaktora [zdjęcia]
16 - Published up: 2022-09-12 16:24:25 - Modified: 2022-09-12 16:24:25 - Feat.: 0 - Title: Za nami XXI Dni Ogrodnika – Targi Międzynarodowe w Gołuchowie
17 - Published up: 2022-09-06 13:50:06 - Modified: 2022-09-06 13:50:06 - Feat.: 0 - Title: Festiwal dyniowy w Małopolsce - odmiany [Zdjęcia]
18 - Published up: 2022-09-06 07:15:20 - Modified: 2022-09-06 07:15:20 - Feat.: 0 - Title: Dzień ziemniaka Agrico [Zdjęcia]
19 - Published up: 2022-08-24 10:58:24 - Modified: 2022-08-24 10:58:24 - Feat.: 0 - Title: Odporne cebule, na worek i do obierania
20 - Published up: 2022-07-25 09:02:21 - Modified: 2022-07-25 09:02:21 - Feat.: 0 - Title: Ogórki w Szczecinie
01 - Published up: 2023-07-25 08:02:05 - Modified: 2023-07-25 08:02:05 - Feat.: 0 - Title: Dzień Ogórka w Szarkówce, 23.07.2023 [zdjęcia]
02 - Published up: 2023-06-09 09:16:14 - Modified: 2023-06-09 09:16:14 - Feat.: 0 - Title: Spotkanie producentów ogórka i pomidora w Iwkowej
03 - Published up: 2023-05-30 14:07:44 - Modified: 2023-05-30 14:07:44 - Feat.: 0 - Title: Targi rolnicze Agriplanta - RomAgroTec w Fundulea w Rumunii
04 - Published up: 2023-05-15 13:26:10 - Modified: 2023-05-15 13:26:10 - Feat.: 0 - Title: Bocheński biznes pomidorowy [zdjęcia]
05 - Published up: 2023-05-08 16:28:56 - Modified: 2023-05-08 16:28:56 - Feat.: 0 - Title: Wielka Majówka Timac Agro Polska
06 - Published up: 2023-05-04 09:13:38 - Modified: 2023-05-04 09:13:38 - Feat.: 0 - Title: Macfrut 2023 - warzywnicze ciekawostki [zdjęcia]
07 - Published up: 2023-05-03 20:12:11 - Modified: 2023-05-03 20:12:11 - Feat.: 0 - Title: Targi MACFRUT 2023, Rimini. Pierwszy dzień targów już za nami [zdjęcia]
08 - Published up: 2023-04-27 16:25:05 - Modified: 2023-04-27 16:25:05 - Feat.: 0 - Title: Agraria 2023 w Rumunii [zdjęcia]
09 - Published up: 2023-04-04 08:59:28 - Modified: 2023-04-04 08:59:28 - Feat.: 0 - Title: Wiosenne Targi Rolno-Ogrodnicze Agromarsz
10 - Published up: 2023-03-21 21:12:51 - Modified: 2023-03-21 21:12:51 - Feat.: 0 - Title: Kieleckie targi AGROTECH 2023 - warzywnicze akcenty [galeria]
11 - Published up: 2023-01-20 15:42:34 - Modified: 2023-01-20 15:42:34 - Feat.: 0 - Title: 13. edycja Targów Sadownictwa i Warzywnictwa - fotorelacja
12 - Published up: 2023-01-13 18:12:31 - Modified: 2023-01-13 18:12:31 - Feat.: 0 - Title: AGRO PREMIERY 2023 w Poznaniu
13 - Published up: 2022-11-07 14:44:53 - Modified: 2022-11-07 14:44:53 - Feat.: 0 - Title: Marchew idealna na przemysł
14 - Published up: 2022-09-14 13:18:25 - Modified: 2022-09-14 13:18:25 - Feat.: 0 - Title: Bardzo dobre ceny cebuli
15 - Published up: 2022-09-12 17:37:39 - Modified: 2022-09-12 17:37:39 - Feat.: 0 - Title: Dni Ogrodnika 2022 - w obiektywie redaktora [zdjęcia]
16 - Published up: 2022-09-12 16:24:25 - Modified: 2022-09-12 16:24:25 - Feat.: 0 - Title: Za nami XXI Dni Ogrodnika – Targi Międzynarodowe w Gołuchowie
17 - Published up: 2022-09-06 13:50:06 - Modified: 2022-09-06 13:50:06 - Feat.: 0 - Title: Festiwal dyniowy w Małopolsce - odmiany [Zdjęcia]
18 - Published up: 2022-09-06 07:15:20 - Modified: 2022-09-06 07:15:20 - Feat.: 0 - Title: Dzień ziemniaka Agrico [Zdjęcia]
19 - Published up: 2022-08-24 10:58:24 - Modified: 2022-08-24 10:58:24 - Feat.: 0 - Title: Odporne cebule, na worek i do obierania
20 - Published up: 2022-07-25 09:02:21 - Modified: 2022-07-25 09:02:21 - Feat.: 0 - Title: Ogórki w Szczecinie